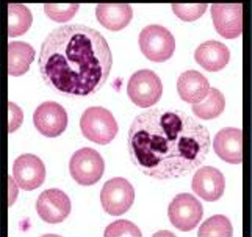
<p>Neutrophil</p>
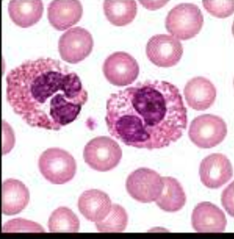
<p>Eosinophils</p>
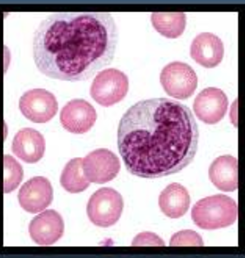
<p>Monocytes</p>
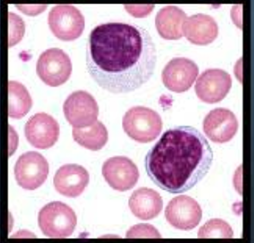
<p>Lymphocytes</p>
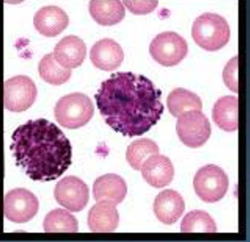
<p>Basophils</p>

Types of White Blood Cells and Their Functions w/ pics
0.0(0)
Studied by 0 peopleCard Sorting
1/4
There's no tags or description
Looks like no tags are added yet.
Last updated 12:40 AM on 4/14/26
Name | Mastery | Learn | Test | Matching | Spaced | Call with Kai |
|---|
No analytics yet
Send a link to your students to track their progress
5 Terms
1
New cards
Neutrophil
Engulfs bacteria and cellular debris
2
New cards
Eosinophils
Identify and destroy parasites, cancer cells and assists basophils with allergic response.
3
New cards
Monocytes
Defend against infection by cleaning up damaged cells.
4
New cards
Lymphocytes
Produces anti-bodies to regulate immune response
5
New cards
Basophils
Produces histamine, response like coughing, sneezing or a runny nose.